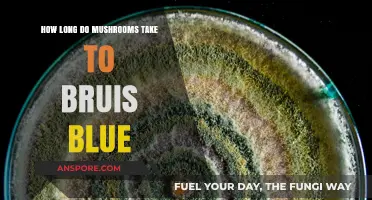
How Long Do Mushrooms Take to Bruise Blue: A Guide

Mushrooms, whether consumed for culinary, medicinal, or psychoactive purposes, can have varying effects on the body, and understanding how long they stay in your system is essential for safety and informed use. The duration mushrooms remain detectable depends on factors such as the type of mushroom, the amount consumed, individual metabolism, and the method of testing. For instance, psilocybin mushrooms, known for their psychoactive properties, are typically processed and eliminated by the body within 24 hours, though traces may be detectable in urine for up to 3 days. In contrast, edible mushrooms like shiitake or button mushrooms are digested more quickly, usually within a few hours. Medicinal mushrooms, such as reishi or lion’s mane, may linger in the system longer due to their bioactive compounds, but their presence is generally not measured in standard drug tests. It’s important to note that while mushrooms may clear the system relatively quickly, their effects, particularly from psychoactive varieties, can last several hours. Always consult a healthcare professional for personalized advice, especially if using mushrooms for medicinal or therapeutic purposes.
| Characteristics | Values |
|---|---|
| Detection Time in Urine | 24-48 hours after ingestion (varies by mushroom type and dosage) |
| Detection Time in Blood | Up to 24 hours after ingestion |
| Detection Time in Hair | Up to 90 days (though hair testing for mushrooms is rare) |
| Metabolism Rate | Depends on mushroom type; psilocybin mushrooms metabolize within hours |
| Half-Life of Psilocybin | Approximately 3 hours (active compound in psilocybin mushrooms) |
| Factors Affecting Duration | Metabolism, body mass, hydration, frequency of use, mushroom potency |
| Elimination Method | Primarily excreted in urine as metabolites |
| Long-Term Presence | No known long-term storage in body tissues |
| Psychoactive Effects Duration | 4-6 hours (psilocybin mushrooms); varies by species and dosage |
| False Positive Drug Tests | Unlikely, as standard tests do not typically screen for mushrooms |
| Legal Detection Context | Rarely tested for in standard drug screenings |
Explore related products
What You'll Learn

Detection Times by Drug Test Type
Urine Tests: Urine tests are the most common method for detecting psilocybin, the active compound in mushrooms. Psilocybin is typically detectable in urine for 12 to 24 hours after ingestion, though this window can vary based on factors like dosage, metabolism, and frequency of use. In rare cases, metabolites of psilocybin may be detectable for up to 3 days, especially in heavy or chronic users. However, standard drug tests often do not screen for psilocybin unless specifically requested, as it is not included in routine panels.
Blood Tests: Psilocybin can be detected in the bloodstream for a shorter period compared to urine. Typically, it is detectable in blood for 1 to 3 hours after ingestion, with its primary metabolite, psilocin, clearing even faster. Blood tests are less commonly used for mushroom detection due to their invasive nature and the short detection window. These tests are more likely to be used in medical or emergency situations rather than routine drug screenings.
Saliva Tests: Saliva tests are less common for detecting mushrooms but can be used in certain situations. Psilocybin may be detectable in saliva for 1 to 2 hours after consumption. The short detection window makes saliva tests less practical for mushroom screening, as the substance is rapidly metabolized and eliminated from oral fluids.
Hair Tests: Hair follicle tests have the longest detection window for drug use, including mushrooms. Psilocybin and its metabolites can be detected in hair for up to 90 days after ingestion. However, hair tests are not frequently used for mushroom detection because they are more expensive and time-consuming than other methods. Additionally, hair tests are more likely to detect chronic or heavy use rather than occasional consumption.
Factors Influencing Detection Times: It’s important to note that individual factors significantly impact detection times across all test types. These include metabolism, body mass, hydration levels, frequency of use, and the potency of the mushrooms consumed. For example, a person with a faster metabolism may eliminate psilocybin more quickly, while a higher dose could extend the detection window. Understanding these variables is crucial when considering how long mushrooms may remain detectable in your system.
In summary, the detection times for mushrooms vary widely depending on the type of drug test used. While urine tests offer a slightly longer detection window, blood and saliva tests are limited to a few hours. Hair tests provide the longest detection period but are rarely used for this purpose. Always consider the specific test being administered and individual factors when assessing how long mushrooms may stay in your system.
Perfectly Cooked Pork Sausage Stuffed Mushrooms: Timing Tips & Tricks
You may want to see also

Factors Affecting Mushroom Metabolism
The duration mushrooms remain in your system is influenced by several factors related to their metabolism. One key factor is the type of mushroom consumed. Psilocybin mushrooms, for instance, contain psychoactive compounds that are metabolized differently than edible varieties like button or shiitake mushrooms. Psilocybin is converted into psilocin in the body, which is then broken down by the liver. This process determines how long the substance stays detectable in your system. Edible mushrooms, on the other hand, are primarily metabolized for their nutritional content, which is processed more quickly.
Another critical factor is individual metabolism. People with faster metabolisms generally process and eliminate substances, including mushrooms, more quickly. Factors such as age, weight, overall health, and liver function play a significant role in how efficiently your body metabolizes mushrooms. Younger individuals or those with a higher metabolic rate may clear mushrooms from their system faster than older adults or those with slower metabolisms. Additionally, pre-existing liver conditions can slow down the detoxification process, prolonging the presence of mushroom compounds in the body.
The dosage and frequency of consumption also significantly impact how long mushrooms stay in your system. Higher doses of psychoactive mushrooms, for example, take longer to metabolize due to the increased amount of psilocybin and psilocin. Similarly, frequent consumption can lead to accumulation of these compounds, extending their detectability. For edible mushrooms, larger portions may take longer to digest but are generally cleared within 24 to 48 hours, depending on individual factors.
Hydration and diet can further influence mushroom metabolism. Staying well-hydrated supports kidney function, aiding in the elimination of metabolites through urine. A diet rich in fiber can also promote faster digestion and excretion of mushroom components. Conversely, dehydration or a diet high in fats may slow down the metabolic process, as the body prioritizes processing other substances over mushroom metabolites.
Lastly, drug interactions and medications can affect how mushrooms are metabolized. Certain medications, particularly those processed by the liver, can interfere with the breakdown of mushroom compounds, potentially prolonging their presence in the system. For example, drugs that inhibit cytochrome P450 enzymes, which are involved in metabolizing psilocybin, can slow down the elimination process. It’s essential to consider these interactions, especially when consuming psychoactive mushrooms, as they can alter both the duration and intensity of their effects. Understanding these factors provides insight into why the time mushrooms remain in your system can vary widely among individuals.
Perfectly Cooked Marinated Mushrooms: Stove-Top Timing Tips and Tricks
You may want to see also

Psilocybin vs. Psilocin Breakdown
When exploring how long mushrooms stay in your system, it’s essential to understand the breakdown of their primary active compounds: psilocybin and psilocin. These compounds are responsible for the psychedelic effects of magic mushrooms, but they differ in their chemical structure, metabolism, and duration in the body. Psilocybin is the prodrug, meaning it is inactive until converted into psilocin, the compound that directly interacts with serotonin receptors in the brain. This conversion occurs primarily in the liver through dephosphorylation.
The metabolism of psilocybin and psilocin is relatively fast compared to other substances. Psilocin has a half-life of about 50 to 75 minutes, meaning it takes this long for half of the compound to be eliminated from the body. Psilocybin’s half-life is slightly longer, around 160 minutes, due to its conversion process. However, both compounds are primarily metabolized by the liver into inactive metabolites, which are then excreted through urine. This rapid metabolism is why the effects of mushrooms typically last 4 to 6 hours, although individual factors like metabolism, dosage, and tolerance can influence duration.
Drug tests for psilocybin and psilocin are less common than tests for substances like cannabis or opioids, but they do exist. Standard drug screenings usually do not detect these compounds, but specialized tests can identify them in urine for up to 24 hours after ingestion. In rare cases, advanced testing methods like hair follicle analysis might detect metabolites for up to 90 days, though this is uncommon. The short detection window is due to the rapid breakdown and excretion of psilocybin and psilocin from the body.
In summary, the Psilocybin vs. Psilocin Breakdown highlights their distinct roles and fates in the body. Psilocybin acts as the precursor, while psilocin is the active agent producing psychedelic effects. Their fast metabolism and excretion mean mushrooms generally stay in your system for a short period, with effects subsiding within hours and detection possible only in the first day or so. Understanding this breakdown is key to grasping how long mushrooms remain detectable and active in the body.
How Long Do Jar Mushrooms Last in the Fridge?
You may want to see also
Explore related products

Short-Term vs. Long-Term Effects
The duration mushrooms stay in your system depends largely on the type of mushroom (psilocybin-containing vs. non-psychoactive) and individual factors like metabolism, dosage, and frequency of use. Psilocybin mushrooms, known for their psychoactive effects, are metabolized relatively quickly, but their short-term and long-term effects differ significantly.
Short-Term Effects (Immediate to 24 Hours):
In the short term, psilocybin mushrooms induce effects within 20–40 minutes of ingestion, peaking around 2–3 hours and lasting up to 6 hours. Users commonly experience altered perception, vivid hallucinations, euphoria, and heightened sensory awareness. Physically, increased heart rate, dilated pupils, and nausea may occur. These effects are primarily due to psilocybin converting to psilocin, which interacts with serotonin receptors in the brain. Non-psychoactive mushrooms, like button or shiitake, have no such effects but are digested similarly to other foods, staying in the system for 24–48 hours. Drug tests can detect psilocybin in urine for up to 24 hours, though this varies based on dosage and metabolism.
Long-Term Effects (Beyond 24 Hours):
Long-term effects of psilocybin mushrooms are less about the substance remaining in the system and more about psychological and neurological changes. Psilocybin is eliminated from the body within 24 hours, but its impact on brain function can persist. Some users report "afterglow" effects, such as improved mood, increased creativity, and enhanced introspection, lasting days to weeks. However, repeated use or high doses may lead to long-term risks, including hallucinogen persisting perception disorder (HPPD), where visual disturbances persist. Non-psychoactive mushrooms, being food, leave no long-term effects unless consumed in excessive amounts, which could cause digestive issues.
Metabolism and Detection:
Psilocybin is metabolized in the liver and excreted in urine, with a half-life of 1–2 hours. Factors like body mass, hydration, and liver health influence how quickly it’s processed. While the substance clears the system within a day, psychological effects can linger. Blood tests can detect psilocybin for up to 12 hours, and hair follicle tests may show usage for up to 90 days, though this is rare. Non-psychoactive mushrooms are not tested for in standard drug screenings.
Short-Term vs. Long-Term Considerations:
Short-term effects of psilocybin mushrooms are intense but temporary, while long-term effects are more nuanced and vary by individual. Non-psychoactive mushrooms have no psychoactive effects and are processed like any other food. Understanding these differences is crucial for safe use and managing expectations, whether for recreational, therapeutic, or dietary purposes. Always consider personal health and legal implications when consuming mushrooms.
How Long Do Mushrooms Take to Kick In?
You may want to see also

Individual Variations in Elimination Rates
The duration mushrooms remain detectable in your system can vary significantly from person to person due to individual differences in metabolism, body composition, and overall health. These variations play a crucial role in determining how quickly psilocybin, the active compound in mushrooms, is processed and eliminated. For instance, individuals with a faster metabolism tend to break down and excrete psilocybin more rapidly than those with a slower metabolism. This metabolic rate is influenced by factors such as age, genetics, and physical activity levels. Younger individuals or those with a naturally higher metabolic rate may eliminate mushrooms from their system in a shorter timeframe compared to older adults or those with a sedentary lifestyle.
Body composition, particularly the ratio of muscle mass to fat, also impacts elimination rates. Psilocybin is lipophilic, meaning it binds to fatty tissues. Individuals with a higher percentage of body fat may retain psilocybin longer, as it accumulates in adipose tissue and is released more slowly into the bloodstream for metabolism. Conversely, those with greater muscle mass and lower body fat may experience faster elimination, as muscle tissue is more metabolically active and aids in the breakdown of substances. Additionally, hydration levels can affect elimination, as adequate water intake supports kidney function, which is essential for excreting metabolites through urine.
Liver health is another critical factor in individual variations. The liver is responsible for metabolizing psilocybin into psilocin, the compound that produces psychoactive effects, and subsequently breaking it down for elimination. Individuals with liver conditions or those who consume substances that strain liver function, such as alcohol or certain medications, may experience slower elimination rates. Conversely, those with a healthy liver typically process and eliminate mushrooms more efficiently. Genetic factors, including variations in enzymes like cytochrome P450, which play a role in drug metabolism, can also influence how quickly psilocybin is cleared from the system.
Frequency of mushroom use and dosage further contribute to individual differences in elimination rates. Chronic users may develop a degree of tolerance, which can affect how their body processes psilocybin. However, repeated use can also lead to accumulation of the substance in fatty tissues, potentially prolonging detection times. Higher doses of mushrooms introduce more psilocybin into the system, which may overwhelm metabolic pathways and result in slower elimination. Conversely, occasional or first-time users typically eliminate mushrooms more quickly, as their bodies are not accustomed to processing the compound.
Finally, overall health and lifestyle choices, such as diet and exercise, can impact how long mushrooms stay in your system. A diet rich in antioxidants and nutrients supports liver function and metabolic processes, potentially speeding up elimination. Regular physical activity enhances circulation and metabolic efficiency, aiding in the breakdown and excretion of substances. Conversely, poor health, malnutrition, or a lack of physical activity can slow down these processes, prolonging the presence of mushrooms in the body. Understanding these individual variations is essential for anyone seeking to predict how long mushrooms will remain detectable in their system.
Extend Mushroom Freshness: Smart Tips for Storing Sliced Mushrooms Longer
You may want to see also
Frequently asked questions
Mushrooms, specifically psilocybin mushrooms, typically stay in your system for 24 to 48 hours, depending on factors like metabolism, dosage, and individual body chemistry.
Standard drug tests (like those for employment) usually do not test for psilocybin or psilocin, the active compounds in mushrooms. However, specialized tests can detect them for up to 3 days after use.
The psychoactive effects of mushrooms typically last 4 to 6 hours, though the duration can vary based on dosage, tolerance, and individual sensitivity.
Yes, different mushroom species and their potency can influence how long they remain detectable in your system. Stronger varieties may take slightly longer to metabolize.
Yes, factors like hydration, metabolism, body mass, and overall health can impact how quickly your body processes and eliminates mushrooms. Staying hydrated may help speed up the process.

![Mushroom Night Light [2 Pack], Plug in Lamp, 8 Color Changing LED Night Lights for Adults Kids Baby Children NightLight Wall Mushroom Decor Lamp for Bedroom Bathroom,Toilet,Stairs,Kitchen,Hallway](https://m.media-amazon.com/images/I/61AFHW4DSTL._AC_UL320_.jpg)